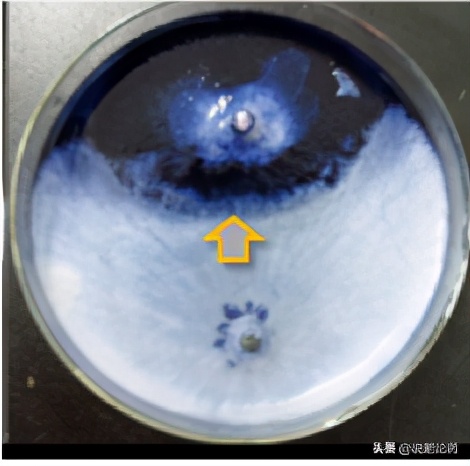
西瓜使用复合微生物肥,西瓜微生物菌剂肥料怎么用

木霉(Trichoderma)是一类重要的具有促进植物生长和防控植物病害的真菌,按传统分类系统,隶属于半知菌亚门(Deuteromycotina)、丝孢纲(Hyphomycetes)、丝孢目(Hyphomycetales)、丝孢科(Hyphomycetaceae),广泛存在于土壤、植物根际、叶面及枯枝落叶等环境中。最常见的木霉有哈茨木霉(T. harzianum)、棘孢木霉(T. asperellum)、绿色木霉(T. viride)、长枝木霉(T. longibrachiatum)和康氏木霉(T. koningi),里氏木霉(T. reesei)等。已有大量的研究表明,木霉对西瓜、甜瓜、花生、豇豆、黄瓜、番茄、芹菜、白菜、菠菜和辣椒等作物有显著的促生效应,并对一些重要的植物病害如枯萎病,根腐病,青枯病具有显著的防效。
一、木霉的形态、生物学特性
木霉属的菌株具有发达的菌丝,菌丝白色,纤细,宽度为1.5~2.4微米。木霉菌落开始时为白色,致密,圆形,向四周扩展,后从菌落中央产生绿色分生孢子,中央变成绿色, 菌落周围有白色菌丝的生长带,最后整个菌落全部变成绿色。分生孢子梗垂直对称分歧,分生孢子单生或簇生,圆形,绿色。绿色木霉菌落外观深绿或蓝绿色,康氏木霉菌落外观浅绿、黄绿或绿色。菌丝生长温度4-42℃,25-30℃生长最快,孢子萌发温度10-35℃,15-30℃萌发率最高,25-27℃下菌落由白变绿只需4-5天。菌丝生长pH值为3.5~5.8,在pH值4~5条件下生长最快。
二、木霉菌剂及木霉生物有机肥的生产
木霉菌株能分泌多种分解纤维素的酶,可以利用作物秸秆如小麦秸秆、水稻秸秆和玉米秸秆加上适量的无机N, P, K肥生产木霉菌剂。物料经过灭菌后调节合适的水分(60%左右),接种木霉菌种(接种量5-10%),铺在发酵床上。木霉菌株是好气性微生物,菌丝生长及孢子形成均需要良好的通气条件,在秸秆等基质上生长时,孢子只在物料表层生长,所以物料不需要铺得太厚。菌丝快速生长需要合适的温度(25-28℃),较高的湿度(相对湿度90-95%)。在合适的温度和湿度下,通常菌丝生长很快,几天内木霉菌丝可遍布整个料面,并很快形成孢子,孢子数量可达109-10/g。将木霉固体菌剂按照一定的比例和有机肥混合就制成了木霉生物有机肥,其中木霉的孢子数需达到或超过国家标准0.2亿/g。

图1 哈氏木霉的菌丝

图2 基质培养的哈氏木霉
三、木霉的促生作用
木霉能产生一些植物生*刺长**激素,如吲哚乙酸,Harzianolide,促进植株根系的发育和生长;分泌植酸酶、嗜铁素,促进植株对P,Fe元素的吸收;分解土壤有机质,增加土壤营养物质的供应,提高作物光合效率,提高植株株高,茎粗等农艺性状,最终达到增产的目的。木霉菌剂或生物有机肥用于西甜瓜育苗,可以提高出苗率,苗生长健壮。木霉菌剂和木霉生物有机肥应用于西甜瓜生产,可促进植株生长,提高光合效率,促进糖分积累,能提高西、甜瓜产量10-20%,并提高果实的糖分。

图3木霉菌剂对西瓜苗的促生作用(左:对照 中:木霉处理 右:对照)

图4 木霉菌剂对西瓜苗根系生长的促生作用(左:对照 中:木霉处理 右:对照)

图5 木霉生物有机肥对宁夏压砂西瓜生长的促生作用

图6 木霉对甜瓜生长的促生作用
四、木霉菌株防控西甜瓜病害
许多木霉菌株可作为生防菌,能防控多种西甜瓜病害,其生防机制主要包括竞争作用,重寄生作用,拮抗作用。
竞争作用木霉菌的重要拮抗机制之一,主要是以抢占空间位点、争夺营养物质的方式来限制植物病原菌的生长。木霉菌株作为腐生性生防真菌,生长、繁殖速度快,可迅速利用土壤中的营养和占据空间位点,能够成功在植株根际定殖,抢占立枯丝核菌、疫霉菌、镰刀菌和腐霉菌等病原菌的生活空间,和病原菌形成竞争关系,从而抑制病原菌的生长。
木霉菌株的重寄生作用包括木霉菌株对病原菌的识别、接触、缠绕、穿透和寄生一系列连续的过程。木霉真菌细胞表面的特定外源凝集素(lectin)在木霉识别病原菌的过程中起到了关键的作用。Elad等(1983)和Harman等(2004)的研究证实,木霉菌对病原菌识别后,能够沿着病原菌的菌丝平行生长或者螺旋状缠绕病原菌生长,同时产生胞状附着物吸附在病原菌菌丝上。张建(2015)的研究表明木霉NJAU 4742有较强的寄生多种植物病原真菌的能力,最后导致病原菌菌丝溶解。高克祥等(2002)在扫描电子显微镜下观察了木霉对5种不同病原菌的重寄生现象,发现病原菌丝上存在溶解位点。Elad等(1999)报道了哈茨木霉菌株T39可以分泌一种蛋白酶来降解灰霉病原菌细胞壁,导致病原菌细胞的破裂,阻止了其对植物细胞的侵染,成功防治了灰霉病害。Djonovic等(2006)报道木霉菌能够分泌β-1,6-葡聚糖酶来破坏腐霉的细胞壁,抑制病原菌的生长。

图7 木霉菌株(绿色荧光蛋白基因标记)沿着尖孢镰刀菌菌丝生长

图8 木霉菌株对一些病原真菌的重寄生作用图8 木霉菌株对一些病原真菌的重寄生作用
(左:枯萎病病原菌-尖孢镰刀菌 右:哈氏木霉NJAU 4742对尖孢镰刀菌的重寄生)
木霉的抗生作用也是其发挥生防作用的重要机制。木霉菌通过产生小分子的抗生素和大分子的抗菌蛋白或胞壁降解酶类来抑制病原菌的生长、繁殖和侵染。据报道,木霉菌可产生30多种抗真菌代谢产物,主要包括了酮类、醇类、内酯类、类萜、多肽等。朱天辉等(1994)的研究指出哈茨木霉的非挥发性代谢产物具有热稳定性,可显著抑制病原菌立枯丝核菌的生长及菌丝干物质积累。屠艳拉(2006)报道了绿色木霉菌株TY009的抗真菌代谢物可以较早抑制水稻纹枯病病原菌立枯丝核菌(Rhizoctonia, HZ001)菌核的形成,降低菌核萌发率。张建等发现木霉菌NJAU 4742可产生大量的H2O2抑制西瓜枯萎病病原菌-的生长。
木霉菌株对西瓜枯萎病病原菌的拮抗作用(上:病原菌 下:木霉NJ4742)
木霉菌株可诱导植物产生防御反应,不仅能直接抑制西瓜枯萎病病原菌-尖孢镰刀菌。据报道,大部分的木霉菌株均可以诱导植物代谢产生变化,表现出明显的诱导抗性作用。Elad等(2000)发现T.harzianum T39的次生代谢产物可以有效抑制病原菌的酶活,使植株产生局部和系统抗病性。黄艳青等(2005)报道了木霉菌能显著诱导甜瓜植株产生抗性反应,有效抵御枯萎病菌的侵染,对甜瓜枯萎病表现出显著的生防效果。国内登记生产木霉菌制剂的企业虽然较少,但木霉菌制剂在市场上的销售增长较为迅速,目前为止,木霉菌生防制剂已占据了真菌杀菌剂近一半的市场份额。


图10 市场上部分木霉菌剂
作者:沈标、田艳丽(南京农业大学)